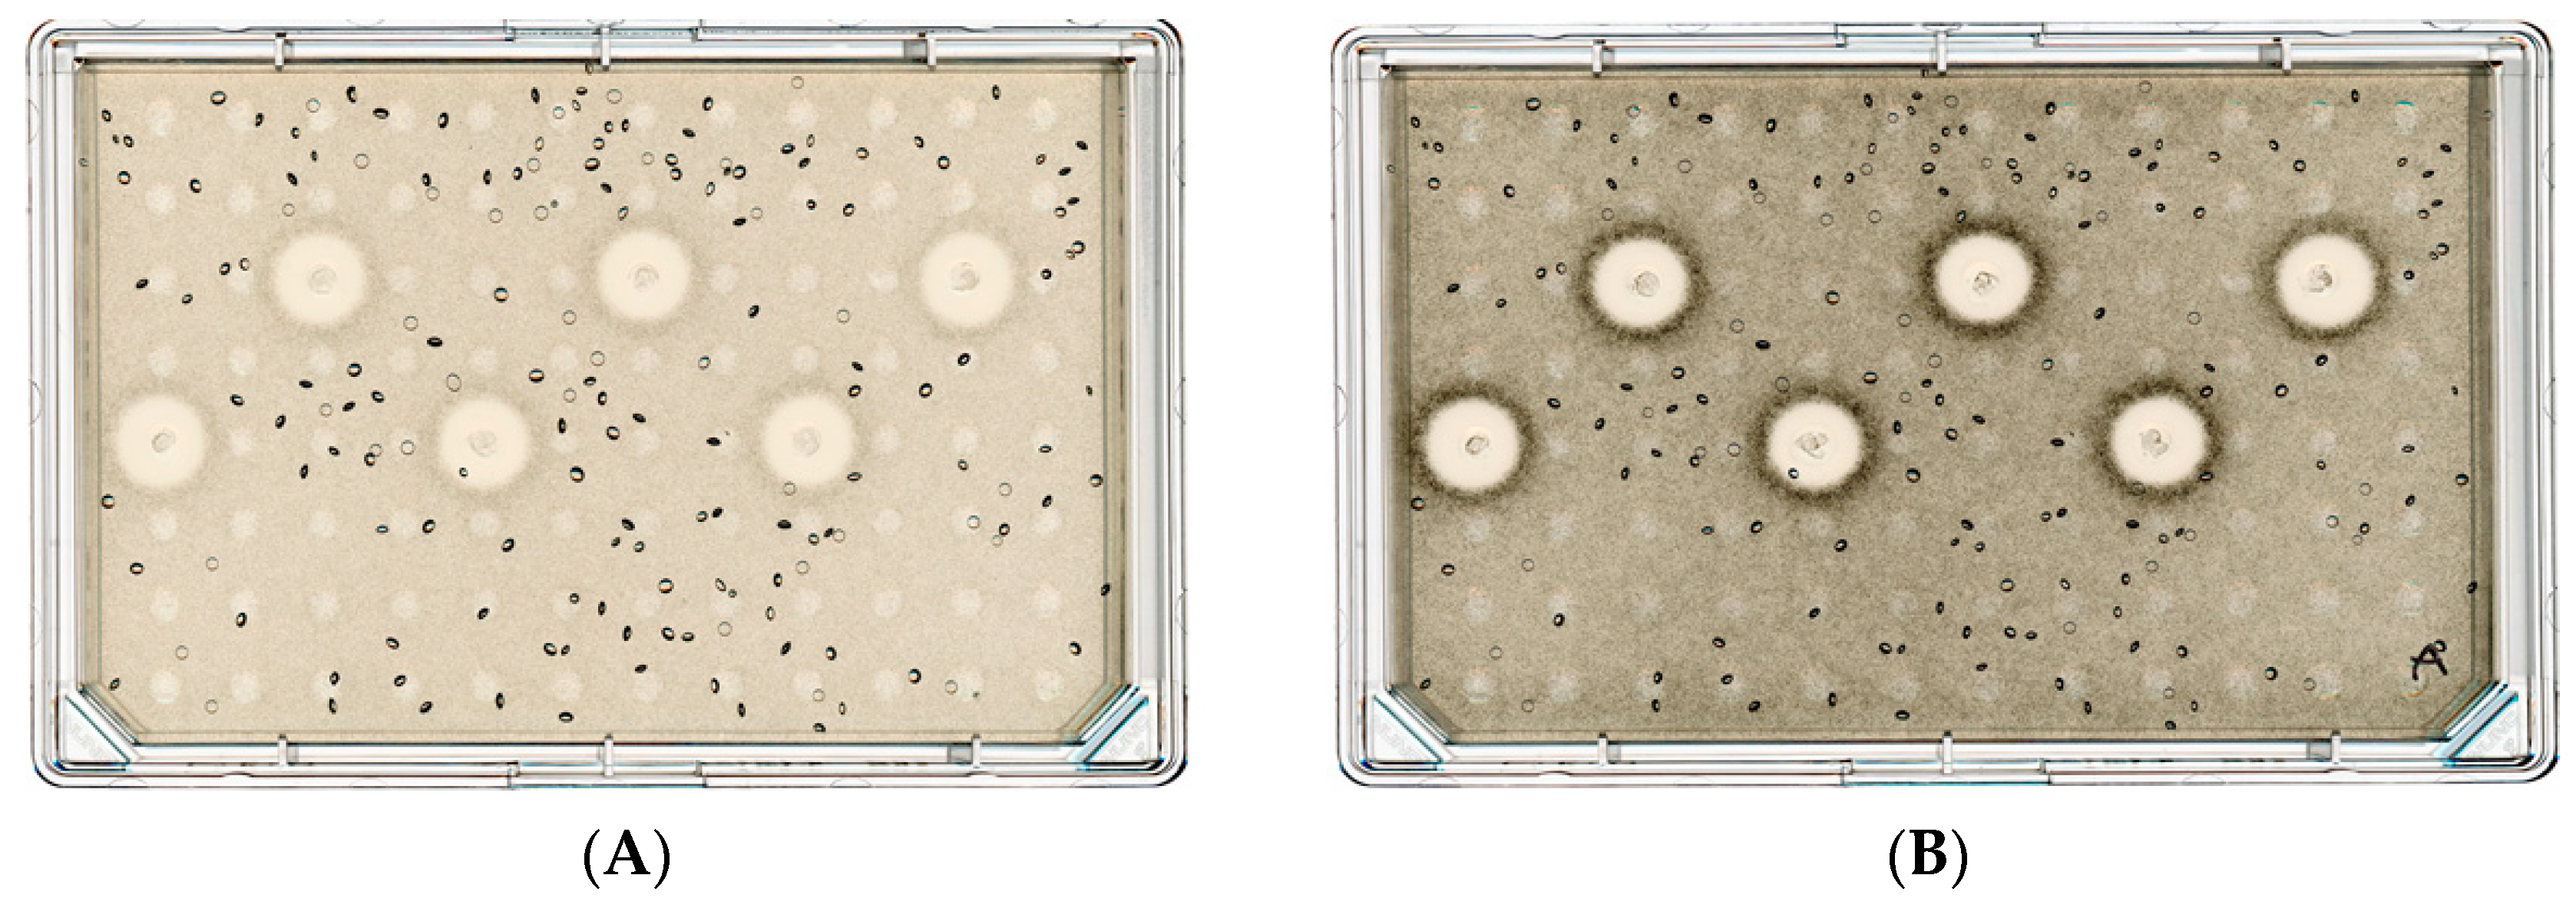
Ruminants 03 00018 g002

A Novel Direct-Fed Microbial for Beef Cattle Has a Supportive Effect against Clostridium perfringens In Vitro and In Vivo
Abstract
1. Introduction
2. Materials and Methods
2.1. Experiment 1—In Vitro
2.2. Experiment 2—Challenge
2.2.1. Animals and Study Design
2.2.2. Treatments
2.2.3. Experimental Challenge
2.2.4. General Health Monitoring
2.2.5. Body Weight
2.2.6. Fecal Sample Collection
2.2.7. Fecal Concentration of Clostridium Perfringens
2.2.8. Statistical Analysis
3. Results
3.1. Experiment 1—In Vitro
3.2. Experiment 2—Challenge
4. Discussion
5. Conclusions
Author Contributions
Funding
Institutional Review Board Statement
Informed Consent Statement
Data Availability Statement
Conflicts of Interest
References
- Hanford, K.J.; Kreikemeier, W.M.; Ware, D. The effects of Bovamine on feedlot performance of finishing cattle: A meta-analysis. J. Anim. Sci. 2011, 89 (Suppl. S1), 258. [Google Scholar]
- Dick, K.J.; Duff, G.C.; Limesand, W.S.; Cuno, S.P.; Knudson, D.K.; McMurphy, C.P.; Hall, L.W.; Bernal-Rigoli, J.C.; Marchello, J.A. Effects of a direct-fed microbial on digestive-tract morphology of Holstein bull calves and performance and carcass characteristics of Holstein. Prof. Anim. Sci. 2013, 29, 107–115. [Google Scholar] [CrossRef]
- Dias, B.G.C.; Santos, F.A.P.; Meschiatti, M.; Brixner, B.M.; Almeida, A.A.; Queiroz, O.; Cappellozza, B.I. Effects of feeding different probiotic types on metabolic, performance, and carcass responses of Bos indicus feedlot cattle offered a high-concentrate diet. J. Anim. Sci. 2022, 100, skac289. [Google Scholar] [CrossRef]
- Cull, C.; Singu, V.K.; Cull, B.J.; Lechtenberg, K.F.; Amachawadi, R.G.; Schutz, J.S.; Bryan, K.A. Efficacy of two probiotic products fed daily to reduce Clostridium perfringens-based adverse health and performance effects in dairy calves. Antibiotics 2022, 11, 1513. [Google Scholar] [CrossRef]
- Cappellozza, B.I.; Copani, G.; Boll, E.J.; Queiroz, O. Supplementation of the direct-fed microbial Enterococcus faecium 669 impacts performance of pre-weaning dairy calves. JDS Commun. 2023, 4, 284–287. [Google Scholar] [CrossRef]
- Food and Agricultural Organization of the United Nations and World Health Organization. 2001. Probiotics in Food: Health and Nutritional Properties of Probiotics in Food Including Powder Milk with Live Lactic Acid Bacteria. World Health Organization. Available online: https://www.fao.org/3/a0512e/a0512e.pdf (accessed on 11 March 2023).
- Markowiak, P.; Śliżewska, K. The role of probiotics, prebiotics and synbiotics in animal nutrition. Gut Pathog. 2018, 10, 21. [Google Scholar] [CrossRef]
- United States Department of Agriculture (USDA). Death Loss in U.S. Cattle and Calves Due to Predator and Nonpredator Causes, 2015; USDA–APHIS–VS–CEAH: Fort Collins, CO, USA, 2015; 85p.
- Glock, R.D.; DeGroot, B.D. Sudden death of feedlot cattle. J. Anim. Sci. 1998, 76, 315–319. [Google Scholar] [CrossRef] [PubMed]
- Songer, J.G.; Meer, R.R. Genotyping of Clostridium perfringens by polymerase chain reaction is a useful adjunct to diagnosis of clostridial enteric disease in animals. Anaerobe 1996, 2, 197–203. [Google Scholar] [CrossRef]
- Revitt-Mills, S.A.; Rood, J.I.; Adams, V. Clostridium perfringens extracellular toxins and enzymes: 20 and counting. Microbiol. Aust. 2015, 36, 114–117. [Google Scholar] [CrossRef]
- Copani, G.C.; Queiroz, O.C.M.; Boll, E.J. Lactobacillus animalis LA51 and Bacillus sp. probiotics confer protection from the damaging effects of pathogenic Clostridium perfringens and Escherichia coli on the intestinal barrier. J. Dairy Sci. 2020, 103 (Suppl. S1), 103. [Google Scholar]
- Segura, A.; Milora, N.; Queiroz, O.; Copani, G. In vitro evaluation of Bacillus licheniformis and Bacillus subtilis enzyme activity, Clostridium perfringens Type A inhibition, and biofilm formation. J. Dairy Sci. 2020, 103 (Suppl. S1), 89. [Google Scholar]
- Santano, N.B.; Boll, E.J.; Capern, L.C.; Cieplak, T.M.; Keleszade, E.; Letek, M.; Costabile, A. Comparative evaluation of the antimicrobial and mucus induction properties of selected Bacillus strains against enterotoxigenic Escherichia coli. Antibiotics 2020, 9, 849. [Google Scholar] [CrossRef]
- FASS. Guide for Care and Use of Agricultural Animals in Research and Teaching, 3rd ed.; Federation of Animal Science Societies: Champaign, IL, USA, 2010. [Google Scholar]
- Blakebrough-Hall, C.; McMeniman, J.P.; González, L.A. An evaluation of the economic effects of bovine respiratory disease on animal performance, carcass traits, and economic outcomes in feedlot cattle defined using four BRD diagnosis methods. J. Anim. Sci. 2020, 98, skaa005. [Google Scholar] [CrossRef] [PubMed]
- Cull, C.; Singu, V.K.; Cull, B.J.; Lechtenberg, K.F.; Amachawadi, R.G.; Schutz, J.S.; Bryan, K.A. Efficacy of Lactobacillus animalis and Propionibacterium freudenreichii-based feed additives in reducing Salmonella-associated health and performance effects in commercial beef calves. Antibiotics 2022, 11, 1328. [Google Scholar] [CrossRef] [PubMed]
- Cull, C.A.; Renter, D.G.; Bello, N.M.; Ives, S.E.; Babcock, A.H. Performance and carcass characteristics of commercial feedlot cattle from a study of vaccine and direct-fed microbial effects on Escherichia coli O157:H7 fecal shedding1. J. Anim. Sci. 2015, 93, 3144–3151. [Google Scholar] [CrossRef]
- Albini, S.; Brodard, I.; Jaussi, A.; Wollschlaeger, N.; Frey, J.; Miserez, R.; Abril, C. Real-time multiplex PCR assays for reliable detection of Clostridium perfringens toxin genes in animal isolates. Vet. Microbiol. 2008, 127, 179–185. [Google Scholar] [CrossRef]
- Filho, E.J.; Carvalho, A.U.; Assis, R.A.; Lobato, F.F.; Rachid, M.A.; Carvalho, A.A.; Ferreira, P.M.; Nascimento, R.A.; Fernandes, A.A.; Vidal, J.E.; et al. Clinicopathologic features of experimental Clostridium perfringens type D enterotoxemia in cattle. Vet. Pathol. 2009, 46, 1213–1220. [Google Scholar] [CrossRef]
- Selim, A.M.; Elhaig, M.M.; Zakaria, I.; Ali, A. Bacteriological and molecular studies of Clostridium perfringens infections in newlyborn calves. Trop. Anim. Health Prod. 2017, 49, 201–205. [Google Scholar] [CrossRef] [PubMed]
- Petit, L.; Gibert, M.; Popoff, M.R. Clostridium perfringens: Toxinotype and genotype. Trends Microbiol. 1999, 7, 104–110. [Google Scholar] [CrossRef]
- Rood, J.I.; Adams, V.; Lacey, J.; Lyras, D.; McClane, B.A.; Melville, S.B.; Moore, R.J.; Popoff, M.R.; Sarker, M.R.; Songer, J.G.; et al. Expansion of the Clostridium perfringens toxin-based typing scheme. Anaerobe 2018, 53, 5–10. [Google Scholar] [CrossRef]
- Goossens, E.; Valgaeren, B.R.; Pardon, B.; Haesebrouck, F.; Ducatelle, R.; Deprez, P.R.; van Immerseel, F. Rethinking the role of alpha toxin in Clostridium perfringens-associated enteric diseases: A review on bovine necro-haemorrhagic enteritis. Vet. Res. 2017, 48, 9. [Google Scholar] [CrossRef]
- Mingmongkolchai, S.; Panbangred, W. Bacillus probiotics: An alternative to antibiotics for livestock production. J. Appl. Microbiol. 2018, 124, 1334–1346. [Google Scholar] [CrossRef] [PubMed]
- Uzal, F.A. Diagnosis of Clostridium perfringens intestinal infections in sheep and goats. Anaerobe 2008, 10, 135–143. [Google Scholar] [CrossRef] [PubMed]
- Luise, D.; Bosi, P.; Raff, L.; Amatucci, L.; Virdis, S.; Trevisi, P. Bacillus spp. probiotic strains as a potential tool for limiting the use of antibiotics, and improving the growth and health of pigs and chickens. Front. Microbiol. 2022, 13, 801827. [Google Scholar] [CrossRef]
- Gupta, M.; Kaur, M.; Gupta, K.G. Lytic effect of Bacillus subtilis elastase on gram-positive and negative bacteria. Indian J. Exp. 1992, 30, 380–383. [Google Scholar]
- Kim, S.-Y.; Ohk, S.-H.; Bai, D.-H.; Yu, J.-H. Purification and Properties of Bacteriolytic Enzymes from Bacillus licheniformis YS-1005 against Streptococcus mutans. Biosci. Biotechnol. Biochem. 1999, 63, 73–77. [Google Scholar] [CrossRef]
- Kung, L.; Stokes, M.R.; Lin, C.J. Chapter 7: Silage additives. In Silage Science and Technology; Buxton, D.R., Muck, R.E., Harrison, J.H., Eds.; American Society of Agronomy, Crop Science Society of America, Soil Science Society of America: St Louis, MI, USA, 2003; Volume 42. [Google Scholar]
- Muck, R.E.; Nadeau, E.M.G.; McAllister, T.A.; Contreras-Govea, F.F.; Santos, M.C.; Kung, L., Jr. Silage review: Recent advances and future uses of silage additives. J. Dairy Sci. 2018, 101, 3980–4000. [Google Scholar] [CrossRef] [PubMed]
- Nekrasov, R.V.; Lozovanu, M.I.; Laptev, G.Y.; Ilina, L.A.; Yildirim, E.A.; Tyurina, D.G.; Melikidi, V.C.; Gorfunkel, E.P.; Filippova, V.A.; Malahov, I.G.; et al. Bioactive feed additive for the prevention of clostridial disease in high-yielding dairy cattle. Agriculture 2023, 13, 786. [Google Scholar] [CrossRef]
- Osorio, J.S. Gut health, stress, and immunity in neonatal dairy calves: The host side of host-pathogen interactions. J. Anim. Sci. Biotechnol. 2020, 11, 105. [Google Scholar] [CrossRef]

| Score | General Health | Hunger | Skin Tent | Dehydration | Appearance |
|---|---|---|---|---|---|
| 0 | Good | Normal suckle, drinking all the MR b | 0–1 s | None | Clean backside, tail, and legs |
| 1 | Mildly depressed | Moderate suckle, but still drinking all the MR | 2–3 s | Mild: possible doubtful eyes, with skin and fur dull | Backside and tail slightly dirty with some sticky feces or dry fecal material |
| 2 | Moderately depressed | Weak suckle, requiring assistance to consume the MR | 3–4 s | Moderate: sunken eyes, reduced skin elasticity, with a dull fur | Backside and tail very dirty, not wet, dying |
| 3 | Severely depressed | Unwilling to suckle, must tube the animal to consume the MR | >4 s | Severe: eyes lie very deep, with a dull fur | Backside, tail, and legs dirty from watery diarrhea |
| 4 a | Moribund or dead | ||||
| Item | CON | DFM 2 | SEM | p= |
|---|---|---|---|---|
| Final BW, kg | 52.6 | 52.8 | 1.94 | 0.96 |
| BW change, kg | 10.0 | 12.7 | 1.93 | 0.35 |
| Item | Treatments | SEM | p= 2 | |||
|---|---|---|---|---|---|---|
| CON | DFM 3 | T | D | T × D | ||
| Daily proportion of calves positive for Clostridial, % | 0.21 | 0.01 | 0.40 | |||
| Day 1 | 80.0 | 70.0 | 14.91 | |||
| Day 2 | 80.0 | 80.0 | 14.91 | |||
| Day 3 | 80.0 | 60.0 | 14.91 | |||
| Day 4 | 70.0 | 50.0 | 14.91 | |||
| Day 7 | 70.0 | 20.0 | 14.91 | |||
| Day 14 | 40.0 | 40.0 | 14.91 | |||
| Item | Treatments | SEM | p= 2 | |||
|---|---|---|---|---|---|---|
| CON | DFM 3 | T | D | T × D | ||
| Mean fecal CFU of Clostridial, log CFU/gram of feces | 0.20 | <0.0001 | 0.51 | |||
| Day 1 | 4.84 | 4.24 | 0.821 | |||
| Day 2 | 4.78 | 4.47 | 0.821 | |||
| Day 3 | 4.14 | 3.26 | 0.821 | |||
| Day 4 | 3.36 | 2.31 | 0.821 | |||
| Day 7 | 3.68 | 0.95 | 0.821 | |||
| Day 14 | 1.92 | 1.23 | 0.821 | |||
| Overall mean | 3.79 | 2.74 | 0.561 | |||
Disclaimer/Publisher’s Note: The statements, opinions and data contained in all publications are solely those of the individual author(s) and contributor(s) and not of MDPI and/or the editor(s). MDPI and/or the editor(s) disclaim responsibility for any injury to people or property resulting from any ideas, methods, instructions or products referred to in the content. |
© 2023 by the authors. Licensee MDPI, Basel, Switzerland. This article is an open access article distributed under the terms and conditions of the Creative Commons Attribution (CC BY) license (https://creativecommons.org/licenses/by/4.0/).
Share and Cite
Guimaraes, O.; Cappellozza, B.I.; Capern, L.C.; Schutz, J.S.; Cull, C.A.; Queiroz, O.; Copani, G. A Novel Direct-Fed Microbial for Beef Cattle Has a Supportive Effect against Clostridium perfringens In Vitro and In Vivo. Ruminants 2023, 3, 189-201. https://doi.org/10.3390/ruminants3030018
Guimaraes O, Cappellozza BI, Capern LC, Schutz JS, Cull CA, Queiroz O, Copani G. A Novel Direct-Fed Microbial for Beef Cattle Has a Supportive Effect against Clostridium perfringens In Vitro and In Vivo. Ruminants. 2023; 3(3):189-201. https://doi.org/10.3390/ruminants3030018
Chicago/Turabian StyleGuimaraes, Octavio, Bruno I. Cappellozza, Lena C. Capern, Jennifer S. Schutz, Charley A. Cull, Oscar Queiroz, and Giuseppe Copani. 2023. "A Novel Direct-Fed Microbial for Beef Cattle Has a Supportive Effect against Clostridium perfringens In Vitro and In Vivo" Ruminants 3, no. 3: 189-201. https://doi.org/10.3390/ruminants3030018
APA StyleGuimaraes, O., Cappellozza, B. I., Capern, L. C., Schutz, J. S., Cull, C. A., Queiroz, O., & Copani, G. (2023). A Novel Direct-Fed Microbial for Beef Cattle Has a Supportive Effect against Clostridium perfringens In Vitro and In Vivo. Ruminants, 3(3), 189-201. https://doi.org/10.3390/ruminants3030018

